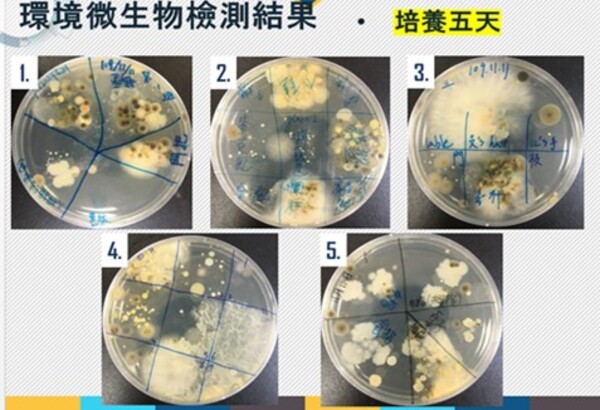

文∕王瑜琦、鄭瑋宜、柯翠玲、王淑綺
.png) 前言
前言
STEAM教育的概念
STEAM為科學(Science)、科技(Technology)、工程(Engineering)、藝術(Art)及數學(Mathematics)五大領域跨學科結合的教育法,起源於2007年美國藝術-國家政策圓桌討論會,是因應要增進學生對科學、技術、工程及數學四種學科(STEM)的學習興趣而產生的學習法(Allina, 2013; Daugherty, 2013; Perignat & Katz-Buonincontro, 2019; Quigley, et al., 2017)。STEAM教育將藝術結合入原本的STEM領域中,以增進學生對課程的參與度、創造力、創新力、批判性思維、協作及問題解決技巧,並增進學生的學習認知、團隊合作、人際溝通技巧及適應力等技能(Burton, et al., 2000; Colucci-Gray, et al., 2017; Hetland & Winner, 2004; Liao, 2016; NAEA, 2016; Root-Bernstein, 2015)。研究也顯示,加入藝術教育可以提升學生對空間推理、抽象思考、發散思維與創造性的自我效能感,及增加對經驗的接受度與好奇心(Swaminathan & Schellenberg, 2015; Torrance, 1972; Winner, et al., 2013)。在美洲原住民的研究中亦顯示,將藝術加入原本生硬的STEM學科中,能使原住民學生對該學科產生更多興趣 (Kant, et al., 2018)。由於在STEAM中對藝術A的定義歷年來多有分歧,Perignat 於2019年則在STEAM的文獻回顧中將「A」綜整定義為三種主要類別:(1)藝術教育(Arts education);(2)任何非STEM以外的學科(Arts as any non-STEM discipline);及(3)任何計畫導向學習(project-based learning)、問題導向學習(problem-based learning)及技術導向的學習或製作等項目(Perignat & Katz-Buonincontro, 2019)。而整體STEAM的概念則是在一個共同的主題下,以STEAM的框架將多個學科結合在一起,兩學科或多學科可以共同合作,以不同視角去了解該主題的概念,但每個學科仍然是獨立的,也就是說,並不會將各學科進行合併(Gershon & Ben-Horin, 2014; Payton, et al., 2017)。
高中微課程的實施理念
微課程(Microcourse)最早由美國教學設計師和線上學習顧問David M. Penrose於2008年首創,意指於1分鐘內簡短講述一個特別的主題,以影音錄製線上教材進行教學,並設計課後作業或活動以引導學生閱讀與自主學習。其目的就是要將複雜的訊息簡短呈現,而可讓學生在短時間內集中注意力獲取資訊整體概要(Shieh, 2009)。這一分鐘對主題的烙印雖然有用,但仍有許多限制,只能概括描述而無法提供較正式的學術指導,因此後來的微課程多定義為不論使用何種上課方式,只要教學時間相對較短,非整學期的課程均可稱為微課程(Educause, 2012; Sweet, 2014)。在高中108課綱中,推行微課程除了可讓高中生提早接觸並選修多元豐富的課程,以引起學生學習興趣與熱忱,亦可讓高中生提早與大學連結,並能藉修課機會與各校學生交流,而能讓高中生對有興趣的領域能有更深入的初步探索與了解,有利於對未來大學之路做定向。
依據教育部「高級中等學校課程規劃及實施要點」第四條規範,學校應依照學生興趣、性向、能力及需求開設多元選修課程,而其開課可與大學院校協調合作,於每週的彈性學習時段,以下述任一種方式開課:
一、 邀請大學教師到高中端開設預修或選修課程
二、 學生赴其他高中跨校共同修課
三、 學生赴開課之大學院校修讀課程 (教育部,2018)。目前高中端的微課程是在每週特定一天的「彈性學習」時段開課,4-6週為一期,每次上課2-3小時,一學期學生總共可選3-4門課程,其開課類型可以為培訓選手、銜接課程、多元試探與先備基礎四種型態。
在本文中,我們以大學教師於高中端所開設之三門基礎醫學選修微課程:微生物、營養及解剖為例,探討基礎醫學課程導入STEAM於高中生微課程之課程設計與學習成效。
.png) 課程一、疫情下之「微」課程~讓高中生認識微生物好友及敵人
課程一、疫情下之「微」課程~讓高中生認識微生物好友及敵人
一、 開課對象:109學年度新化高中與新莊高中多元選修微課程學生
二、 開課週數:4週 (8小時)
三、 授課方式:知識解說(物理、化學、生物學、食品科學、科技生活)、影片欣賞、探究實作(動手、實作、分組討論、跨領域統整思考、口語表達)
四、 運用STEAM的比例:S: 40%、T: 20%、E: 10%、A: 15%、M: 15%
疫情之下,大家聞「病菌」色變,微生物似乎成為眾矢之的,各式各樣的消毒殺菌方式紛紛出籠,然而近年來的研究顯示人體身上共存的微生物對於人體的各項生理作用扮演重要的角色,許多不該被殺死的微生物正被人類過度清潔消毒下逐漸失去平衡。本文作者於109學年度,有機會參與新化高中、新莊高中多元選修微課程,故以STEAM教育模式設計規劃課程讓高中生認識微生物。本微課程以「專題導向學習」、「解決真實世界問題」、「動手實作」、「團隊協作」的課程情境,除了教導正確的認知,也訓練學生養成批判性思考、創意、科技設計、構思概念等的知能。課程首先基本認識微生物,並由學生自主設計方式,進行環境及人體微生物採集及培養的實作課程。之後融入生活中常見的微生物控制法,讓學生以團隊合作方式設計實作條件,來試驗物理及化學性控制因子對微生物生長之影響。另一方面,藉由實作教案設計,讓學生了解微生物在食品醫學及藝術相關方面的應用情形,同時也激發學生的創新創意。最後以分組主題探討方式,引導學生在各情境及場域觀察並了解到這些亦敵亦友且無所不在的微生物。在課程實施過程中,學生的提問、討論及最後一週的分組討論和分享,可以感受出學生對於微生物觀念的改變,課後回饋表單也顯示學生增加對於微生物的認識。期望未來能修正並優化課程,且能讓更多高中生參與,培育更多有正確微生物觀念的防疫及應用達人。
表1. 「亦敵亦友的微生物」主題式STEAM課程發展理念表
圖1. 學員們聆聽教師解說人體微生物相
圖1. 學員們聆聽教師解說人體微生物相
 圖2. 各組環境微生物採樣培養五天後的成果
圖2. 各組環境微生物採樣培養五天後的成果
 圖3. 學員們觀看分組進行之控制微生物方法實作結果
圖3. 學員們觀看分組進行之控制微生物方法實作結果
 圖4. 分組上臺分享各篇章內的微生物好友及敵人的種類與特性
圖4. 分組上臺分享各篇章內的微生物好友及敵人的種類與特性
.png) 課程二、「STEAM」與營養之火花~從我的餐盤談起
課程二、「STEAM」與營養之火花~從我的餐盤談起
一、 開課對象:109學年度新化高中與新莊高中多元選修微課程學生
二、 開課週數:5週 (10小時)
三、 授課方式:知識解說(營養科學、食物學、歷史)、探究實作(動手實作、跨領域統整思考、生活應用、口語表達)
四、 運用STEAM的比例:S: 40%、T: 20%、E: 10%、A: 10%、M: 20%
十二年國民基本教育新課綱鼓勵高中發展跨領域專題實作活動,開啟了大學與高中的跨域合作,利用彈性課程的時間,融入不同領域專業知識,期望提升學生的學習動機與視野。本文作者於109學年度,參與新化高中、新莊高中多元選修微課程,將STEAM的「跨領域」、「動手做」、「生活應用」、「解決問題」、「五感學習」等五大精神融入營養專業課程中,以均衡飲食為主軸,導入「我的餐盤」觀念,課程設計由繪本開始並讓學生用蠟筆進行創意發想,也運用桌遊來提升學習興趣與強化記憶,最後與生活經驗連結。在課程實施後,參與課程的高中生明顯瞭解我的餐盤各區塊所對應的食物類別,並且正確的將食物歸類,也能熟記餐盤的六大口訣;此外,在課程執行中可以覺察學生逐步思考如何將理論的知識活用在生活中,在小組討論及上臺分享,可以訓練學生溝通與表達能力,掌握如何在有限的時間內聚焦自己的想法,顯示運用STEAM精神結合理論專業知識,能提升學生學習動機及強化知識與生活的結合。期望未來能導入更多的營養專業知識,內化學生的知識,從而在生活中落實,徹底實現均衡飲食、健康生活的目標。
表2. 「我的餐盤」主題式STEAM課程發展理念表

 圖5. 學員們上臺跟同學分享營養繪本
圖5. 學員們上臺跟同學分享營養繪本
 圖6. 學員們發揮創意,繪製心中的理想餐盤,並且上臺分享。
圖6. 學員們發揮創意,繪製心中的理想餐盤,並且上臺分享。
.png) 課程三、以生活中的「黑白切」引導高中生認知人體構造中之STEAM
課程三、以生活中的「黑白切」引導高中生認知人體構造中之STEAM
一、 開課對象:109學年度暑期高中營隊學生
二、 授課天數:2天 (14小時)
三、 授課方式:知識解說(解剖學、組織學、生理學)、探究實作(實際操作、跨領域思考、口語表達)
四、 運用STEAM的比例:S: 45%、T: 15%、E: 15%、A: 20%、M: 5%
108課綱中的「核心素養」為培養學子解決生活中遭遇困難與面對不可預測的未來挑戰時所需具備的知識、能力、與態度。強調與生活的關聯性,不侷限於學科科目冷僻學識之專研。本高中營隊校園活動即以普羅大眾平民小吃黑白切作為媒介,進行人體結構之推廣介紹,符合108課綱之基本精神。同時營隊活動也嘗試導入STEAM教育模式設計活動,並以實作及遊戲為學習活動主軸,期望高中生能運用生活中的素材與資訊,在愉快的氛圍中學習一般人較少觸及的人體解剖學。
本營隊為期二天、分三階段、共計十四小時活動。單次活動人數約40人,可由高中生物老師帶領或網路自由報名參與。多數學生歷經此校園營隊活動後對解剖學不再感到陌生與距離感,多具備對解剖學的基本認知,因此對解剖學產生更多的學習動機與興趣。而教師不僅從中獲得學生正面的評價鼓舞,因此也激盪更多的教學創新思維,整體教學策略更具應變與創新之能量,進而優化常態課堂之教學。
表3. 活動表

 圖7. 學員們正運用相關圖卡進行辨識與小組合作學習
圖7. 學員們正運用相關圖卡進行辨識與小組合作學習
 圖8. 運用「黑白切」食材豬內臟模擬大體解剖實驗之步驟與手法,並觀察學習與人體結構相似之構造。
圖8. 運用「黑白切」食材豬內臟模擬大體解剖實驗之步驟與手法,並觀察學習與人體結構相似之構造。
 圖9. 結合電子切片網站資源與實體顯微鏡及組織切片進行人體微觀構造之觀察學習
圖9. 結合電子切片網站資源與實體顯微鏡及組織切片進行人體微觀構造之觀察學習
.png) 結論
結論
本文中我們使用 STEAM 教育為理念,應用於高中微課程上,期望能成為一種有效的教學法,能有效提升高中學生的創造力、批判性思維和其他技能。